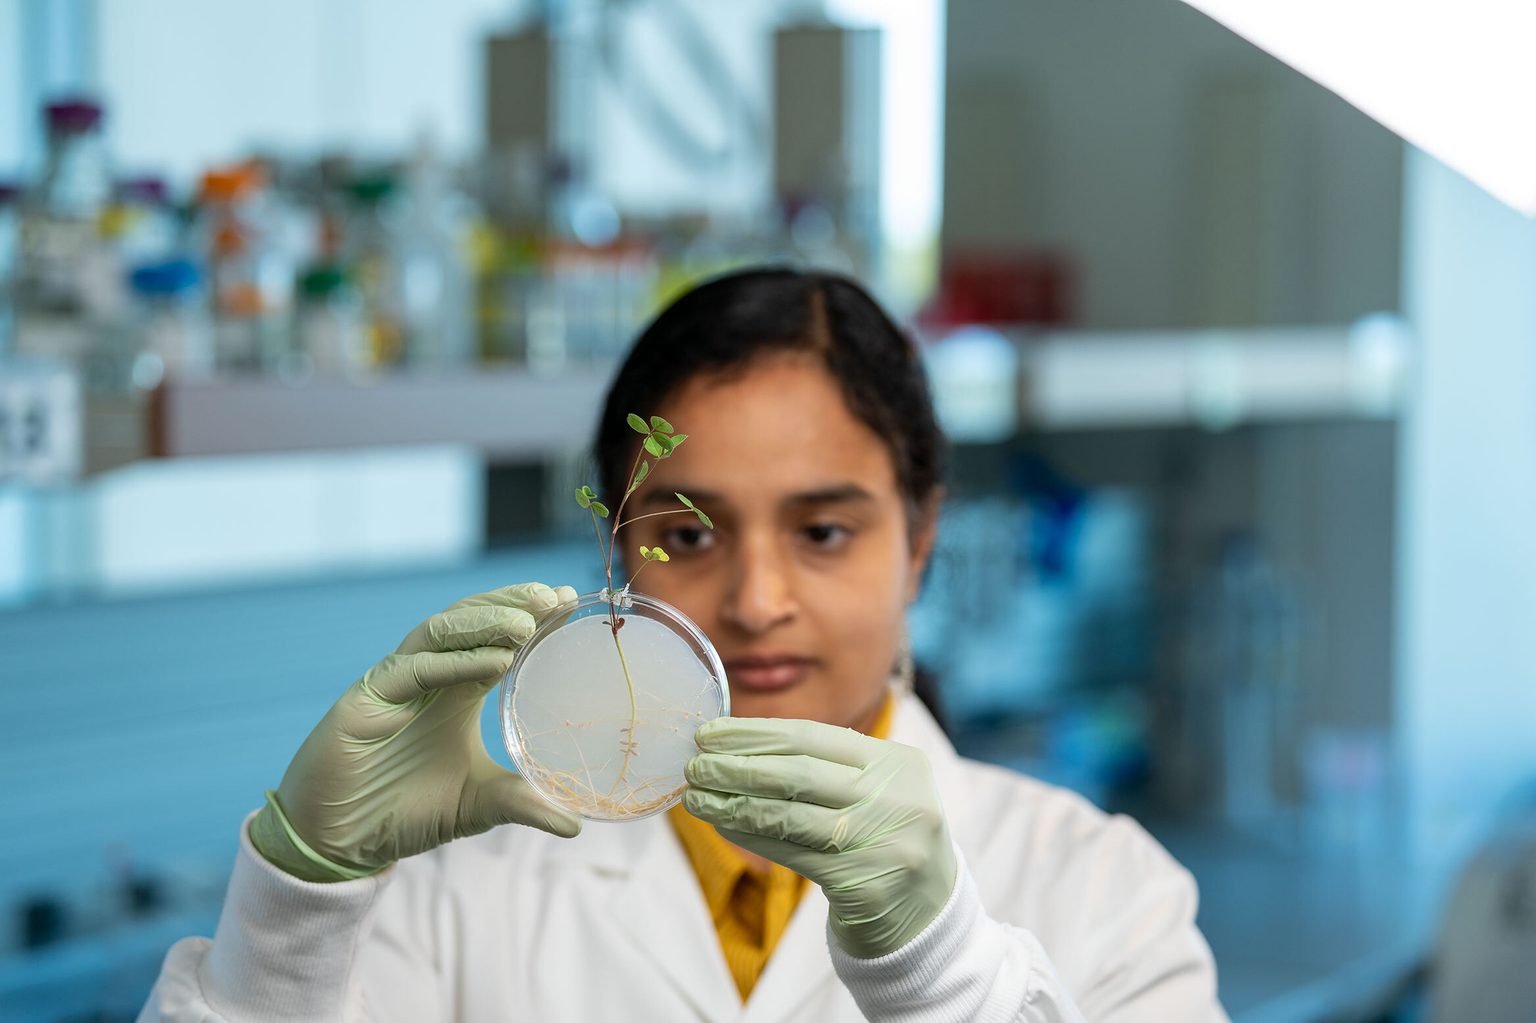

In The News

14 June 2026
From Argentina to Kansas City: Stowers Scientist Luciana Castellano's Scientific Journey
Argentine News Outlet Todo Noticias Features Stowers Scientist Luciana Castellano, Ph.D.
Read Article
#Stowers25: Celebrating 25 Years
Jim and Virginia Stowers envisioned a world-class research institute in Kansas City with a mission to unravel the secrets of life. Making their mission a reality required a deliberate commitment to hire the brightest scientists and invest heavily in technology to support innovation.
By Rachel Scanza, Ph.D.
For 25 years, the Stowers Institute for Medical Research has thrived because of a radical idea: build world-class Technology Centers, staffed by experts, that allow Investigators to tackle biology once thought impossible. It was a risky experiment. But it worked. This model, established at the Institute’s founding, remains its cornerstone today.
“The Technology Centers and our scientific expertise are the secret sauce of the Institute,” said Investigator and Scientific Director Emeritus Robb Krumlauf, Ph.D. “I was delighted to find that Jim was always fascinated by technology — he appreciated that technology could go hand in hand with enabling entrepreneurial science.”

Investigator and founding Scientific Director Robb Krumlauf, Ph.D.
From the beginning, these core labs helped accelerate the Institute’s research. For example, a state-of-the-art microscopy center partnered with the lab of Investigator Linheng Li, Ph.D., to enable the first visualization of a supportive “home” where blood stem cells live in bone marrow. What had once been an elusive concept — the stem cell niche — became a visible reality.
The Technology Centers have evolved throughout the past two-plus decades. “Initially, Technology Centers focused on providing service and instrumentation support,” explained Chief Operating Officer Brian Slaughter, Ph.D. “Over the years, we transitioned to recruiting scientists who are now part of the research programs of our Investigators, proposing experiments and publishing collaborative papers. It is truly a unique model to invest so heavily in not just equipment but talent.”

Robotic pipetting in the Automation and PCR Technology Center.
That pairing of technology and talent continues to drive innovation. “The ever-expanding capabilities of technology have been, and will always be, a basic tenet of the Institute’s success,” said Scientific Advisory Board (SAB) Member Michael Levine, Ph.D., Professor of Genomics at Princeton University.
Stowers technology even extends to nature itself. A vast variety of creatures are housed at the Institute — from planarians and apple snails to coral, plants, and some of the most ancient life forms, such as bacteria and viruses — each carefully chosen to answer a specific biological question. Planarians, for example, can regrow entire bodies from tiny fragments, while apple snails have become a new system for studying eye formation and repair, both offering windows into regeneration. Specialized husbandry and infrastructure support these organisms, which exemplifies how technology and biology intersect at the Institute.

Investigator Linheng Li, Ph.D.
Essentially, this means pursuing science without limitations. “We don't ask our researchers to study a question based on which research organism is already here,” said Slaughter. “Rather we ask, ‘What would you like to study?’ and ‘What research organism is best to study that?’ This leads to fascinating research projects with huge potential for impact.”
Looking ahead, the Institute is investing in artificial intelligence (AI) to accelerate discovery. “Science is driven by technology. From day one, the vision was to have core facilities that would transform and enable the science of the Investigators,” said Eric Olson, Ph.D., SAB Chairman and Chair of Molecular Biology at UT Southwestern Medical Center. “AI is the future — to the extent that those new technologies can be integrated into the Stowers research efforts, I think the sky’s the limit.”

For President and Chief Scientific Officer Alejandro Sánchez Alvarado, Ph.D., the future of biology demands a broadened scope. “The most impactful science is going to come from individuals who harness technology to marry the interface between cellular and molecular biology with systems and environmental biology.”
After 25 years, the Institute continues to adapt yet remains committed to making the impossible possible. Sánchez Alvarado recalled establishing apple snails as a novel research organism, but his thought conveys the spirit of all the Institute’s achievements, from the Stowers’ original vision to the present and far into the future: “It was a big risk, but it worked.”
In The News

14 June 2026
Argentine News Outlet Todo Noticias Features Stowers Scientist Luciana Castellano, Ph.D.
Read Article
Press Release
12 June 2026
Stowers Institute scientists discover that immune cells grow more prominent with age and reshape the tissue environment that supports developing eggs — offering new clues for future research on reproductive aging, ovarian health, and infertility.
Read Article
News

04 June 2026
Postdoc Profile: Jorge Moreno on his Stowers research experience — “a place where unconventional ideas are encouraged and explored.”
Read Article
